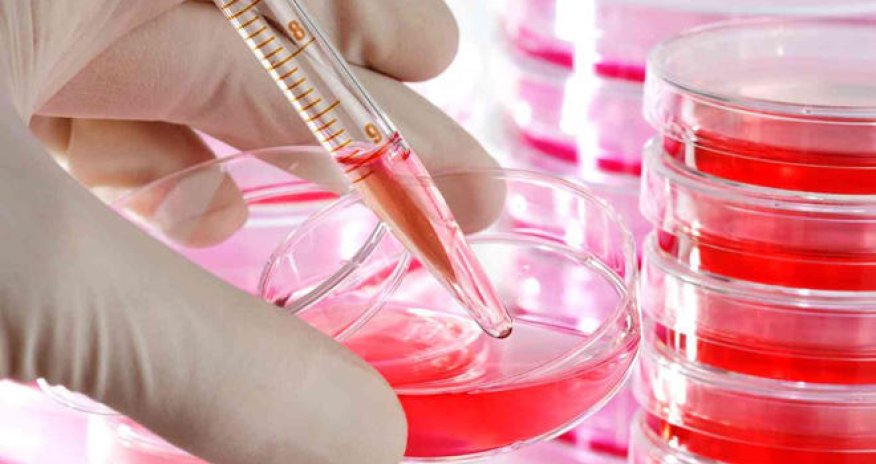
Agency for Agrarian Services talks spread of anthrax among cattle in Azerbaijan (EXCLUSIVE)

Agency for Agrarian Services talks spread of anthrax among cattle in Azerbaijan (EXCLUSIVE)
No cases of infection or death of cattle from anthrax have been recorded in Azerbaijan since 2005, spokesman for the Agency for Agrarian Services under Azerbaijan’s Agriculture Ministry Yolchu Khanvali told Trend.
According to him, the epizootic situation in Azerbaijan associated with anthrax, as well as other infectious diseases of livestock, is currently stable.
Noting that the causative agents of ulcers can live in the soil for centuries, Khanvali said that preventive measures are being taken regularly to prevent animals from becoming infected with this and other dangerous diseases.
He noted that 2,530,204 large-horned cattle, 7,185,984 small ruminants, 81,363 dry-grained, 4,105 pigs and 320 camels were vaccinated against anthrax this year alone.
Two people have recently been diagnosed with anthrax in Azerbaijan’s Sabirabad, one of whom passed away.
According to statistics, 10 people were infected with anthrax in 2014, 9 in 2015, 10 in 2016, 6 in 2017, 9 in 2018, and 7 in 2019. Based on the available data, anthrax infections have not been fatal to this day.
www.anews.az




































 Photo
Photo 



 Video
Video 

